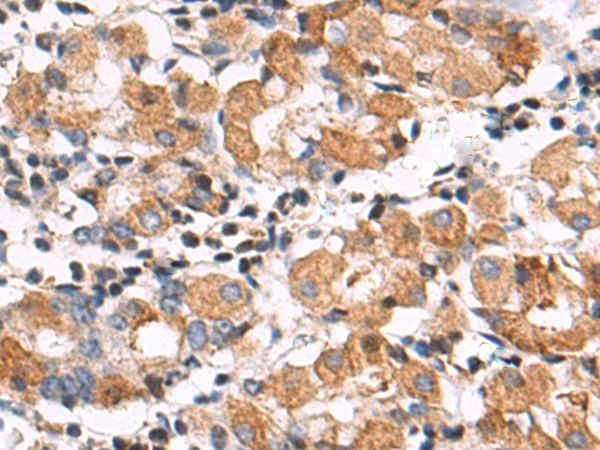
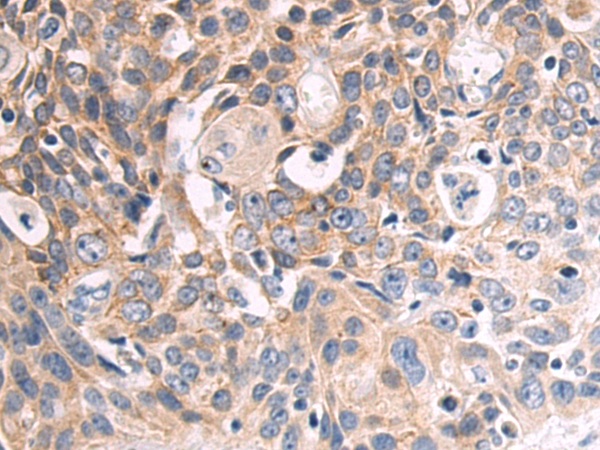

别名:IFNA; IFNA2B; leIF A; IFN-alphaA; IFN-alpha-2应用:WB,IHC
反应种属:Human
规格:50μl/100μl
| Description |
|---|
| This gene is a member of the alpha interferon gene cluster on chromosome 9. The encoded cytokine is a member of the type I interferon family that is produced in response to viral infection as a key part of the innate immune response with potent antiviral, antiproliferative and immunomodulatory properties. This cytokine, like other type I interferons, binds a plasma membrane receptor made of IFNAR1 and IFNAR2 that is ubiquitously expressed, and thus is able to act on virtually all body cells. The encoded protein is effective in reducing the symptoms and duration of the common cold and in treating many types of cancer, including some hematological malignancies and solid tumors. A deficiency of type I interferon in the blood is thought to be a hallmark of severe COVID-19 and may provide a rationale for a combined therapeutic approach. |
| Specification | |
|---|---|
| Aliases | IFNA; IFNA2B; leIF A; IFN-alphaA; IFN-alpha-2 |
| Swissprot | P01563 |
| WB Predicted band size | 22 kDa |
| Host/Isotype | Rabbit IgG |
| Storage | Store at 4°C short term. Aliquot and store at -20°C long term. Avoid freeze/thaw cycles. |
| Species Reactivity | Human |
| Immunogen | Fusion protein of human IFNA2 |
| Formulation | pH7.4 PBS, 0.05% NaN3, 40% Glycerol |
| Application | |
|---|---|
| WB | 1/500-1/2000 |
| IHC | 1/50-1/200 |
| ELISA | 1/2000-1/5000 |
![]() |
Gel: 12%SDS-PAGE, Lysate: 40 μg, Lane: 293T cell lysate, Primary antibody: P02737(IFNA2 Antibody) at dilution 1/1000, Secondary antibody: Goat anti rabbit IgG at 1/5000 dilution, Exposure time: 5 minutes |
![]() |
The image is immunohistochemistry of paraffin-embedded Human gastric cancer tissue using P02737(IFNA2 Antibody) at dilution 1/65. (Original magnification: ×200) |
![]() |
The image is immunohistochemistry of paraffin-embedded Human esophagus cancer tissue using P02737(IFNA2 Antibody) at dilution 1/65. (Original magnification: ×200) |
本公司的所有产品仅用于科学研究或者工业应用等非医疗目的,不可用于人类或动物的临床诊断或治疗,非药用,非食用。
暂无评论
本公司的所有产品仅用于科学研究或者工业应用等非医疗目的,不可用于人类或动物的临床诊断或治疗,非药用,非食用。
中文

发表回复